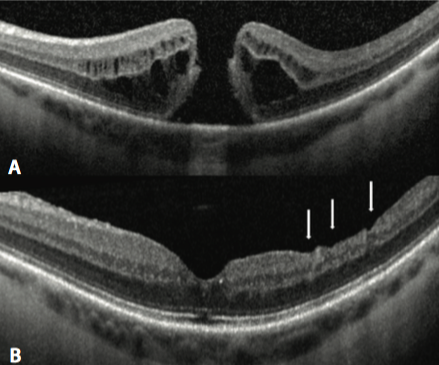
Resultado de imagen de macular hole

Durante muchos años el debate sobre los resultados de la cirugía del agujero macular estaba fundamentado sobre el hecho de pelar o no la membrana limitante interna (MLI), sin embargo como ya vimos en la entrada de mi Blog anterior, desde la introducción por Eckard del pelado de la MLI, se aumentó el éxito anatómico en un 92%, posteriormente siguieron muchos otros artículos aleatorizados y meta-análisis¹ que así lo confirman, demostrando que el pelado de la MLI en la práctica clínica ha mejorado los resultados quirúrgicos siendo superiores al 90%, contra un 50 -70% de cierre del agujero macular sin el pelado de la MLI. Por otro lado la tasa de reoperación del agujero macular es de 0,39% en ojos sometidos a pelado de MLI y de 7,2% en ojos sin pelado de MLI. También existe una creciente preocupación de acuerdo al posible daño irreversible en la retina por la extracción de la MLI, se ha demostrado la presencia de microescotomas paracentrales, los cuales han sido detectados con microperimetría sobre las retinas denudadas de MLI.

Teniendo claro que el pelado de la MLI se ha convertido en el gold standard del tratamiento del agujero macular, una de las interrogantes a conocer era saber con precisión cuánta MLI habría de quitar. Recientemente se ha publicado un articulo por la revista Retina². El cual tenía como objetivo analizar la influencia del tamaño del pelado de la MLI sobre los resultados en la cirugía del agujero macular.
Fue un estudio prospectivo, comparativo e intervencional, se incluyeron 50 pacientes, dividiendo 2 grupos, el grupo 1 con 25 ojos de pelado pequeño (3mm) y mientras el grupo 2 de 25 ojos con pelado grande (5 mm). En los resultados se obtuvo que las tasas de cierre del agujero macular eran similares en ambos grupos sin ser significativas (p=0,20). Ninguna diferencia se encontró con respecto al éxito anatómico, respecto al tamaño, estadio o duración del agujero. La agudeza visual fue mejor en el grupo 1 (4 lineas vs 2 lineas del ETDRS P= 0,04); la capa de fibras nerviosas fue más delgada en el grupo 2 (5mm), en la región a 2.5 mm temporal donde fue significativo, (P < 0.05), mientras que la capa de células ganglionares fue más gruesa en el grupo de 3mm en región temporal predominantemente.
Este reciente estudio prueba claramente que el hecho de incrementar el tamaño del pelado no influye sobre la tasa de cierre anatómica, independientemente del tamaño, duración o fase de evolución del agujero y si puede influir negativamente sobre el grosor de la capa de fibras nerviosas y de células ganglionares.
La reciente evidencia muestra que aunque el pelado de la MLI no mejore los resultados sobre la agudeza visual, si lo es respecto a los resultados anatómicos, siendo por lo tanto más favorable en términos de costo-efectividad, por incrementar la probabilidad de cierre anatómico. Sin embargo debemos hacer una lectura cuidadosa recordando que en el agujero macular el pelado de la MLI, se debe procurar mantener un tamaño tan pequeño como sea posible, justo lo suficiente para liberar la tracción tangencial alrededor del agujero y maximizar los resultados funcionales sin comprometer las tasas de éxito de cierre quirúrgico primarias.
Si tienes alguna pregunta, duda o comentario puedes escribirnos en nuestro muro de facebook:
![]()
Bibliografía:
1.- Spiteri Cornish K, Lois N, Scott N, et al. Vitrectomy with internal limiting membrane (ILM) peeling versus vitrectomy with no peeling for idiopathic full-thickness macular hole (FTMH). Cochrane Database Syst Rev. 2013;6.
2.- Aditya Modi, Anantharaman Giridhar, Mahesh Gopalakrishnan, Comparative Analysis Of Outcomes With Variable Diameter Internal Limiting Membrane Peeling In Surgery For Idiopathic Macular Hole Repair, Retina 37:265–273, 2017.
Guardar